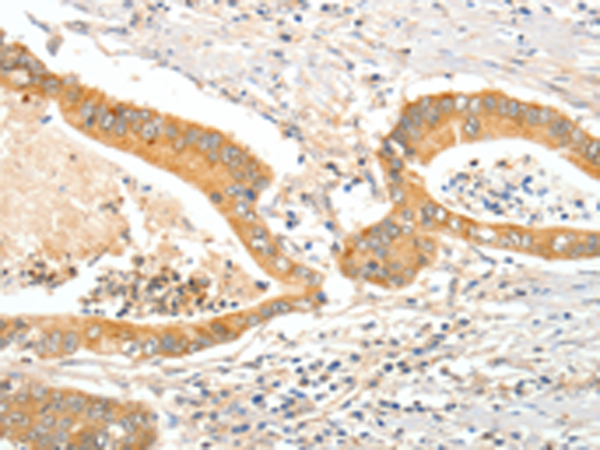

中文名稱:兔抗APOB多克隆抗體
|
IHC Recommend dilution: |
15-50 |
|
IHC positive control: |
Human colon cancer and Human thyroid cancer |
|
ELISA Recommended dilution: |
1000-5000 |
|
SwissProt: |
P04114 |
|
Synonyms: |
FLDB; LDLCQ4 |
|
Full name: |
apolipoprotein B (including Ag(x) antigen) |
|
Immunogen: |
Synthetic peptide of human APOB |
|
Name of antibody: |
APOB |
|
Applications: |
ELISA, IHC |
|
Background: |
This gene product is the main apolipoprotein of chylomicrons and low density lipoproteins. It occurs in plasma as two main isoforms, apoB-48 and apoB-100: the former is synthesized exclusively in the gut and the latter in the liver. The intestinal and the hepatic forms of apoB are encoded by a single gene from a single, very long mRNA. The two isoforms share a common N-terminal sequence. The shorter apoB-48 protein is produced after RNA editing of the apoB-100 transcript at residue 2180 (CAA->UAA), resulting in the creation of a stop codon, and early translation termination. Mutations in this gene or its regulatory region cause hypobetalipoproteinemia, normotriglyceridemic hypobetalipoproteinemia, and hypercholesterolemia due to ligand-defective apoB, diseases affecting plasma cholesterol and apoB levels. |
購物車
購物車 幫助
幫助
 021-54845833/15800441009
021-54845833/15800441009
